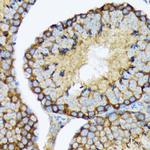
USP9X Antibody in Immunohistochemistry (Paraffin) (IHC (P))

Search
Invitrogen
USP9X Recombinant Rabbit Monoclonal Antibody (7T0S2)
{{$productOrderCtrl.translations['antibody.pdp.commerceCard.promotion.promotions']}}
{{$productOrderCtrl.translations['antibody.pdp.commerceCard.promotion.viewpromo']}}
{{$productOrderCtrl.translations['antibody.pdp.commerceCard.promotion.promocode']}}: {{promo.promoCode}} {{promo.promoTitle}} {{promo.promoDescription}}. {{$productOrderCtrl.translations['antibody.pdp.commerceCard.promotion.learnmore']}}
产品信息
MA5-38217
种属反应
宿主/亚型
Expression System
分类
类型
克隆号
抗原
偶联物
形式
浓度
纯化类型
保存液
内含物
保存条件
运输条件
RRID
产品详细信息
Positive Samples: 293T, PC-3, C6, U-251MG, Mouse testis, Mouse brain
Immunogen sequence: MTATTRGSPV GGNDNQGQAP DGQSQPPLQQ NQTSSPDSSN ENSPATPPDE QGQGDAPPQL EDEEPAFPHT DLAKLDDMIN RPRWVVPVLP KGELEVLLEA
靶标信息
USP9X is an ubiquitin-specific protease involved in the removal and recycling of ubiquitin from proteins degraded in proteasomes. As a deubiquitinating enzyme, USP9x has a critical function in tight junction biogenesis by controlling the levels of the exchange factor for Arf6 (EFA6), a protein shown to facilitate tight junction formation during a narrow temporal window preceding the establishment of cell polarity. USP9X is also located on the X-chromosome but escapes X-inactivation, and defects in USP9X may cause gonadal degeneration in Turner syndrome.
仅用于科研。不用于诊断过程。未经明确授权不得转售。
篇参考文献 (0)
生物信息学
蛋白别名: Deubiquitinating enzyme FAF-X; Drosophila fat facets related, X-linked; Fat facets homolog; Fat facets in mammals; fat facets protein related, X-linked; Fat facets protein-related, X-linked; fats facets protein related, X; hFAM; probable ubiquitin carboxyl-terminal hydrolase FAF-X; Ubiquitin carboxyl-terminal hydrolase 9X; Ubiquitin carboxyl-terminal hydrolase FAM; ubiquitin specific peptidase 9, X chromosome; ubiquitin specific protease 9 SSSRF- isoform; ubiquitin specific protease 9, X chromosome; ubiquitin specific protease 9, X chromosome (fat facets-like Drosophila); Ubiquitin thioesterase FAF-X; ubiquitin thiolesterase FAF-X; ubiquitin-specific processing protease FAF-X; Ubiquitin-specific protease 9, X chromosome; Ubiquitin-specific-processing protease FAF-X
基因别名: 5730589N07Rik; AA407302; AA407699; AL022658; AL022749; DFFRX; FAF; FAF-X; Fafl; FAM; MRX99; MRXS99F; RGD1560056; USP9; USP9X
UniProt ID: (Human) Q93008, (Mouse) P70398
Entrez Gene ID: (Human) 8239, (Mouse) 22284, (Rat) 363445